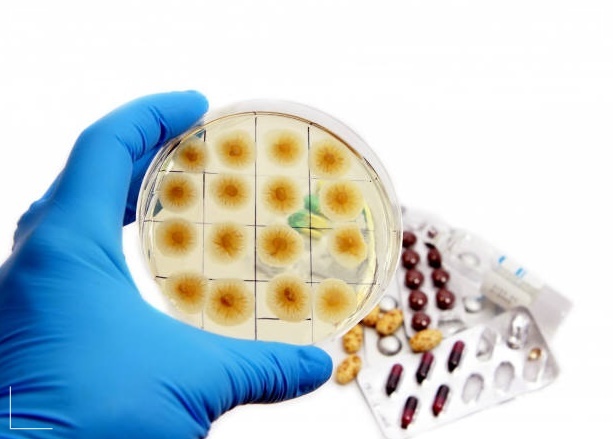

코로나19의 감염환자가 지속적으로 늘어나면서 장기화에 대한 우려가 더 높아지고 있습니다. 이런 가운데 중국 환구시보가 지난 5일 내몽고에서 '림프절 페스트’로 의심되는 환자가 발견됐다고 전함에 따라 중국이 발칵 뒤집어졌습니다.


흑사병의 발병원인과 증상 예방법에 대해 확인하시고 미리 예방하시기 바랍니다.
중국에서 흑사병 발병
최근 코로나19 환자가 다시 늘어남에 따라 중국 당국의 격리 및 방역지침이 강화되고 있는 상황 속에 전해진 흑사병 소식에 중국 전체가 긴장하는 모습입니다. 신종 코로나바이러스 감염증(코로나19)으로 인한 피해 수습이 채 끝나기도 전에 이 같은 소식이 전해지자 중국 방역 당국은 비상이 걸렸습니다.




지난 해 코로나 발생전 흑사병 발생
묘한 점은 코로나19가 방생하기 전인 지난해 11월에도 중국 네이멍구에서 2명의 흑사병 환자가 발생해 베이징에서 치료 받고 있다는 소식이 전해진바 있습니다. 이에 앞서 그해 9월에도 흑사병으로 1명이 사망했다고 중국 국가위생건강위원회가 밝혔습니다.




흑사병이란?
흑사병이란 중세 유럽 인구의 3분의 1을 감소시켜 인류 역사상 최악의 전염병으로 손꼽히는 페스트는 림프절 페스트, 폐 페스트, 패혈증 페스트 등으로 나뉩니다.
-림프절 페스트
림프절 페스트는 이미 페스트균에 감염된 포유동물이나 벼룩에 물려서 발생하는 경우가 많고, 일반적으로 2~6일 잠복기 이후 오한, 38도 이상의 발열, 근육통, 관절통, 두통 등이 나타납니다.
증상 발생 후 24시간 이내에 페스트균이 들어간 신체 부위 국소 림프절에 통증이 생깁니다.




-패혈성 페스트
패혈성 페스트는 증상이 발열, 구역, 구토, 복통, 설사 등 일반적인 패혈증(균이 전신으로 퍼지는 것) 증상과 같습니다. 출혈성 반점, 상처 부위 출혈, 혈관 내 응고증에 의한 말단부 괴사, 치료가 잘 되지 않는 저혈압, 콩팥 기능 저하, 쇼크 등이 생길 수 있습니다.

-폐 페스트
폐 페스트는 가장 증상이 심한데 페스트균에 감염된 환자나 동물의 호흡기 분비물에 의한 감염이 가능하다고 알려졌습니다. 잠복기는 3~5일이고 갑자기 발생하는 오한, 발열, 두통, 전신 무력감 등이 발생합니다.


빠른 호흡, 호흡 곤란, 기침, 가래, 흉통이 나타날 수도 있으며 질병 이틀째부터는 객혈, 호흡 부전, 심혈관계 부전, 허탈 등이 생길 수 있습니다
흑사병의 발병 원인
이번에 내몽고에서 발견된 의심 사례는 림프절 페스트로, 페스트균에 감염된 포유동물이나 벼룩에 물려서 발생하는 세균성 질병입니다. 일반적으로 2~6일 잠복기 이후 38도 이상의 발열, 오한, 근육통, 관절통, 두통 등의 증상이 나타납니다.


제때 치료하면 증상이 빠르게 호전되지만 그렇지 않으면 패혈증이 진행되고 다발 장기부전 등으로 성인이 24시간 안에 사망에 이를 수 있습니다.


인간과 인간 감염
림프절 페스트는 인간과 인간 사이에서도 감염이 되기 때문에 각별한 주의가 요구된다며 예방수칙을 지켜달라고 당부하고 있습니다.
흑사병 치료
흑사병은 혈액이나 림프액, 가래 등을 받아 페스트균 배양 검사를 시행해 확진한다. 치료는 항생제를 투여해 진행합니다. 발병 초기에 치료를 시작하면 효과적인 치료가 가능해 되도록 조기에 정확하게 진단하는 것이 중요합니다.